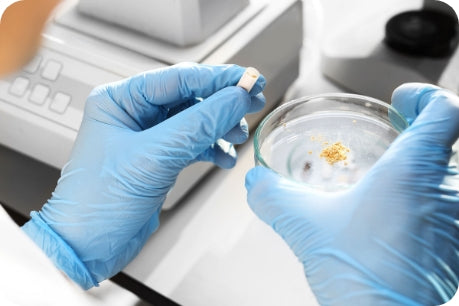

GLP-1 drugs (Ozempic, Mounjaro, Wegovy, etc.): These medications may be costly and do not address the underlying causes of weight gain or teach you how to keep the weight off long-term. They rely on turning off your body’s natural hunger signal, interrupting the gut-brain connection. Because these drugs suppress your appetite, they may prevent you from getting the essential nutrients your body needs and put you at risk for potential side effects. Worse, once the medication is stopped, many people regain the weight — creating long-term dependency, which benefits the pharmaceutical industry.
Apps like WW (Weight Watchers) or NOOM: Once known for promoting lifestyle changes, these platforms are now heavily marketing GLP-1 drugs — signaling a lack of confidence in their core programs. Users are not only paying for subscriptions but also face added costs from telehealth consultations and expensive medications. We believe prescribing these drugs is not only irresponsible but may put your long-term health at risk.
Processed meal replacement snacks and prepackaged diet meals: These products are marketed as convenient weight loss solutions, but they’re often made with cheap ingredients, chemicals, additives, artificial preservatives, and sauces high in sugar or sodium. Despite their high cost, they offer minimal nutritional value and do little to support lasting, healthy habits. While they may lead to temporary weight loss, regaining weight once you return to regular eating is inevitable — and the health trade-offs can be significant.